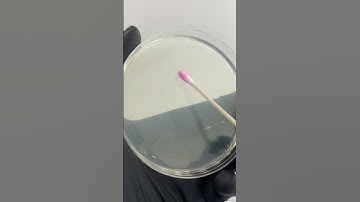
What should I test next? #ulta #bacteria

⬇ DOWNLOAD NOW
Kalau muncul iklan pop-up, tutup lalu klik tombol kembali
Download lagu Streamline Your Microbial Quality Control Testing with MicroQuant™ secara gratis hanya untuk keperluan promosi. Dukung artis favorit kamu dengan membeli musik original di iTunes atau platform resmi lainnya.
 Streamline Microbial QC Testing Using MicroQuant™ by ATCC
Streamline Microbial QC Testing Using MicroQuant™ by ATCC
 Membrane filtration using EZ-Fit® single-use filtration units
Membrane filtration using EZ-Fit® single-use filtration units
 Microbiological Quality Assessment
Microbiological Quality Assessment
What should I test next? #ulta #bacteria
What should I test next? #ulta #bacteria
 Microbiological Quality Control of Liquid Samples in Pharma-Compliant Industry
Microbiological Quality Control of Liquid Samples in Pharma-Compliant Industry
 Microbial Quality Control in Manufacturing of Medicinal Products
Microbial Quality Control in Manufacturing of Medicinal Products
 Compact Dry: Food Microbiology Testing Made Easier with R-Biopharm
Compact Dry: Food Microbiology Testing Made Easier with R-Biopharm
 Testing Procedures and #Quality Assurance in #microbiology Laboratory
Testing Procedures and #Quality Assurance in #microbiology Laboratory